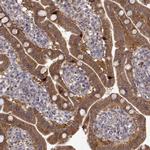
DOPA Decarboxylase Antibody in Immunohistochemistry (Paraffin) (IHC (P))
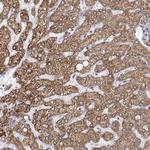
DOPA Decarboxylase Antibody in Immunohistochemistry (Paraffin) (IHC (P))

Search
Invitrogen
DOPA Decarboxylase Polyclonal Antibody
{{$productOrderCtrl.translations['antibody.pdp.commerceCard.promotion.promotions']}}
{{$productOrderCtrl.translations['antibody.pdp.commerceCard.promotion.viewpromo']}}
{{$productOrderCtrl.translations['antibody.pdp.commerceCard.promotion.promocode']}}: {{promo.promoCode}} {{promo.promoTitle}} {{promo.promoDescription}}. {{$productOrderCtrl.translations['antibody.pdp.commerceCard.promotion.learnmore']}}
产品信息
PA5-82597
种属反应
宿主/亚型
分类
类型
抗原
偶联物
形式
浓度
规格
纯化类型
保存液
内含物
保存条件
运输条件
RRID
产品详细信息
Immunogen sequence: LETVMMDWLG KMLELPKAFL NEKAGEGGGV IQGSASEATL VALLAARTKV IHRLQAASPE LTQAAIMEKL VAYSSDQAHS SVERAGLIGG VKLKAIPSDG NFAMRASA
Highest antigen sequence indentity to the following orthologs: Mouse - 90%, Rat - 88%.
靶标信息
DOPA Decarboxylase (aromatic L-amino acid decarboxylase, AADC; DDC) catalyzes the second reaction in the biosynthesis of catecholamines and serotonin (Waymire and Haycock, 2002; Berry et al., 1996; Haycock et al., 2003). It is also involved in the biosynthesis of trace amines. DDC antibodies can therefore be used as markers for dopaminergic, noradrenergic and serotonergic neurons in a variety of applications including depression, schizophrenia, Parkinson's disease and drug abuse (Kish et al., 2001; Zhu et al., 2000; Zhu et al., 1999).
仅用于科研。不用于诊断过程。未经明确授权不得转售。
篇参考文献 (0)
生物信息学
蛋白别名: AADC; Aromatic-L-amino-acid decarboxylase; DDC; DOPA decarboxylase; dopa decarboxylase (aromatic L-amino acid decarboxylase); dopa decarboxylase (aromatic L-amino acid decarboxylase) isoform DDC_1; dopa decarboxylase (aromatic L-amino acid decarboxylase) isoform DDC_2; HGNC:2719; unnamed protein product
基因别名: AADC; DDC
UniProt ID: (Human) P20711
Entrez Gene ID: (Human) 1644